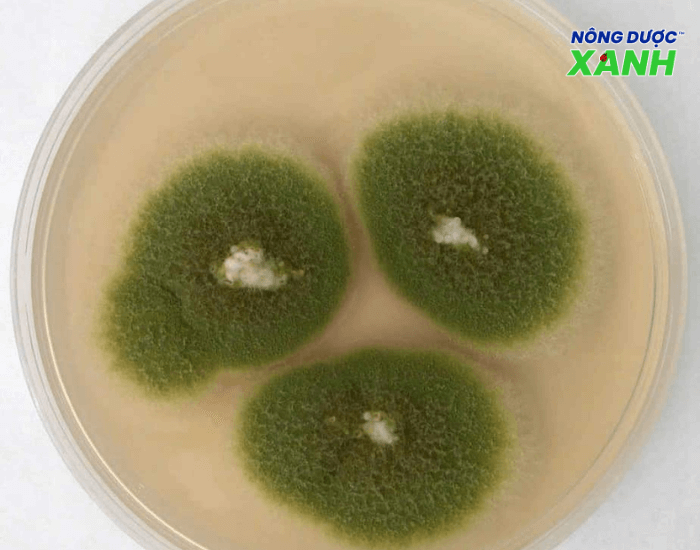
uploads2f20242f082f022f1272b29adb06b9e143fa80b2e3f8c22c121ac26d2fnam-doi-khang-aspergillus nam-doi-khang-aspergillus.png

Nấm đối kháng là gì?
Nấm đối kháng là chủng nấm vi sinh tiêu diệt, ngăn chặn sự phát triển các loại nấm gây bệnh, không cho xâm nhập vào vùng rễ, thân, và lá cây trồng, mang lại nhiều lợi ích.
Có khoảng 300 loài nấm thuộc 113 chi được xác định là nấm đối kháng, 9 chi tiềm năng: Alternaria, Aspergillus, Candida, Fusarium, Penicillium, Pichia, Talaromyces, Trichoderma và Verticillium. Trong đó, Trichoderma là nổi bật nhất.
Các chi nấm gây bệnh phổ biến mà nấm đối kháng thường được dùng để kiểm soát: Alternaria, Botrytis, Colletotrichum, Fusarium, Lasiodiplodia, Penicillium, Phytophthora, Sclerotinia.
Nấm đối kháng Aspergillus
Cơ chế hoạt động của nấm đối kháng là gì?
Cơ chế nấm đối kháng là ngăn ngừa sự lây nhiễm của mầm bệnh vào cây chủ hoạt động trực tiếp hoặc gián tiếp, bao gồm:
- Kháng sinh: Nấm đối kháng sản xuất ra các chất phá hủy tế bào bệnh, ngăn cản chúng phát triển và lan rộng.
- Ký sinh nấm: Nấm đối kháng sẽ hút chất dinh dưỡng từ vi khuẩn có hại nhằm làm yếu hoặc giết chết mầm bệnh.
- Tạo sức đề kháng: Nấm đối kháng kích thích cây phản ứng phòng vệ, sản xuất các chất kháng khuẩn tự nhiên chống lại mầm bệnh.
- Tăng cường sinh trưởng: Tác nhân kiểm soát sinh học thúc đẩy sinh trưởng của cây qua việc sản xuất auxin (axit indoleacetic), axit gibberellic.
- Tiết ra các enzyme: Các enzyme như chitinase và glucanase được nấm đối kháng tạo ra để phân giải thành phần cấu trúc mầm bệnh, làm suy yếu và tiêu diệt vi sinh vật bệnh.
- Cạnh tranh về không gian và chất dinh dưỡng: Nấm đối kháng cạnh tranh trực tiếp với mầm bệnh làm giảm sự sinh trưởng, lan rộng nấm có hại.
- Giải độc: Chất đối kháng vi sinh vật trung hòa hoặc phân hủy độc tố do mầm bệnh tiết ra giảm khả năng gây hại của chúng đối với cây chủ.

Cơ chế hoạt động của nấm đối kháng
Nấm đối kháng dùng để làm gì trong nông nghiệp?
Ứng dụng nấm đối kháng là một phần quan trọng trong quản lý dịch hại giảm sự phụ thuộc vào hóa chất nông nghiệp. Những lợi ích khi dùng:
- Kiểm soát mầm bệnh: Nấm đối kháng giúp kiểm soát các mầm bệnh gây hại cho cây trồng, giảm thiểu thiệt hại do bệnh tật gây ra.
- Thúc đẩy sinh trưởng: Sức khỏe cây trồng được cải thiện nhờ nấm đối tiết ra các chất kích thích sinh trưởng, tăng khả năng hấp thụ dinh dưỡng cho cây.
- Cải thiện chất lượng đất: Sử dụng nấm đối kháng cải thiện cấu trúc đất, độ tơi xốp và khả năng giữ nước, đồng thời giảm sự phát triển của vi sinh vật có hại trong đất.
Sử dụng nấm đối kháng đạt hiệu quả
Khi dùng nấm đối kháng trong nông nghiệp bà con tuân thủ các hướng dẫn và khuyến cáo của nhà sản xuất để đảm bảo hiệu quả và an toàn cho cây trồng.
Liều lượng sử dụng
Tùy theo lượng nấm đối kháng có trong mỗi chế phẩm, bà con nông dân cần làm theo hướng dẫn của nhà sản xuất, đảm bảo nấm có lợi phát huy tối đa hiệu quả trong việc kiểm soát mầm bệnh và thúc đẩy sinh trưởng của cây.
Phương pháp áp dụng
Nấm đối kháng có tác dụng cao khi được trộn cùng phân chuồng để bón vào đất. Phân chuồng là nguồn dinh dưỡng cho nấm phát triển và giúp chúng phân hủy nhanh chóng các chất hữu cơ khi này đất trở nên màu mỡ hơn.
Pha loãng chế phẩm nấm đối kháng với dung dịch nước đường theo tỷ lệ khuyến cáo, ủ dung dịch trong 12-24 giờ để nấm đối kháng phát triển. Cách này giúp tăng số lượng nấm và nhanh chóng phát huy hiệu quả.
Tưới dung dịch nấm đối kháng vào gốc cây ở giai đoạn cây con bảo vệ cây khỏi bệnh chết rũ hiệu quả. Số lần sử dụng và thời điểm bổ sung nấm phụ thuộc vào thời gian sinh trưởng và giai đoạn mẫn cảm với bệnh chết rũ của từng loại cây.

Ứng dụng nấm đối kháng
Những điều cần lưu khi sử dụng nấm đối kháng là gì?
Vì là chế phẩm sinh học, nấm đối kháng có một số đặc điểm cần lưu ý khi sử dụng để đạt hiệu quả cao nhất:
- Hạn chế trộn trực tiếp với phân bón hóa học hoặc thuốc bảo vệ thực vật hóa học vì sẽ làm giảm hoạt tính của nấm.
- Nếu cần phải bón phân hoặc phun thuốc trừ sâu hóa học, nên dùng cách nhau 2-3 ngày để đảm bảo nấm không bị ảnh hưởng.
- Không nên sử dụng nấm đối kháng đã quá hạn sử dụng vì có thể không còn tác dụng.
- Bảo quản nấm đối kháng nơi khô ráo, thoáng mát, tránh ánh nắng trực tiếp và xa các sản phẩm hóa học.
- Bổ sung nấm đối kháng vào đất để xử lý mầm bệnh trước khi gieo trồng.
Với sự nắm rõ nấm đối kháng là gì cũng như sử dụng đúng cách loại nấm này sẽ tối ưu năng suất cây trồng, sản phẩm chất lượng cao, giảm thiểu chi phí quản lý dịch bệnh.
Bà con cần tìm hiểu thêm các sản phẩm thuốc trừ sâu sinh học hãy liên hệ ngay với Nông dược XANH qua số hotline 09.6661.6664 để được tư vấn chi tiết và hoàn toàn miễn phí.
Mua chung giá tốt
Hệ thống cửa hàng
Kiến thức nông nghiệp